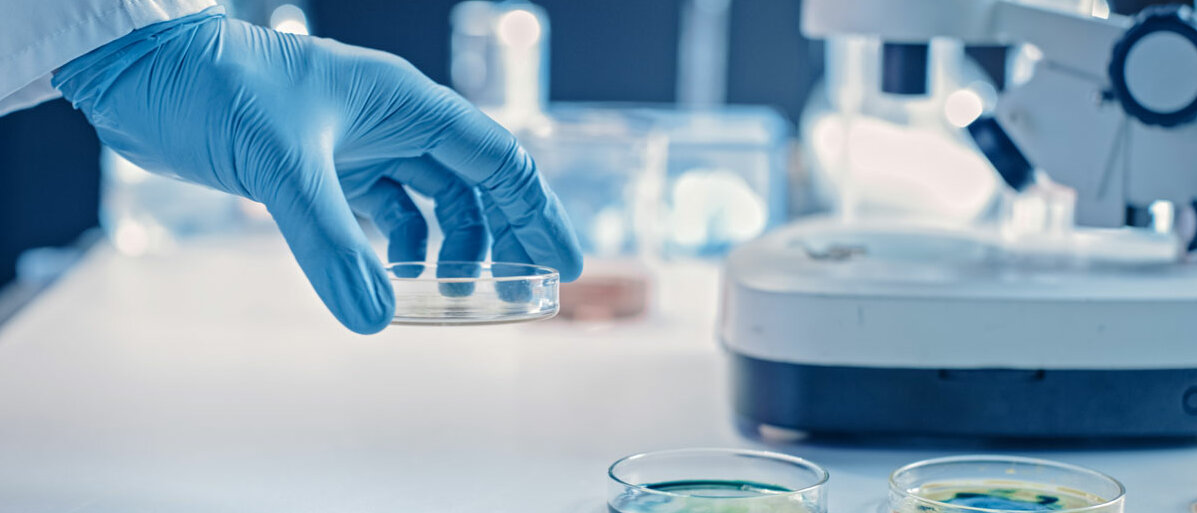

Resistenzen
ALTERNATIVE ZU ANTIBIOTIKA KOMMT AUS DEM BODEN
Seite 1/1 2 Minuten
Bacteriocine heißen diese Wunderwaffen im Kampf gegen (resistente) Erreger. In der Lebensmittelindustrie haben sie sich zur Konservierung schon als nützlich erwiesen. Diese potenziellen Wirkstoffe stammen nicht aus dem Reagenzglas, sondern werden von gentechnisch veränderten Bodenbakterien (Corynebacterium glutamicum) produziert. Denn einzelne Bakterienstämme bleiben gerne unter sich. Nähern sich ihnen „Fremderreger“ bilden sie antimikrobielle Substanzen, um das Ausbreiten der Feinde zu verhindern. Bei diesen Subtanzen handelt es sich um die beschriebenen Bacteriocine.
Ein Forscherteam aus Ulm hat es mit Hilfe des gentechnisch veränderten Stammes geschafft, Bacteriocine in Reinform herzustellen. „Für die klinische Anwendung solcher Bacteriocine braucht es neuartige, großtechnische Verfahren, die es möglich machen, die Effizienz der Produktion und die Reinheit des Stoffes massiv zu verbessern“, erklärt Professor Christian Riedel vom Institut für Mikrobiologie und Biotechnologie an der Universität Ulm. Denn bislang ist die Produktion aufwändig, das Resultat nicht rein genug. Um das gesamte medizinische Potenzial der Substanz auszunutzen, müssen neue Methoden her. Dafür schuf das Forscherteam aus Ulm, mit Unterstützung von Fachkolleg*innen aus Deutschland, Norwegen, Dänemark und Österreich nun die Voraussetzungen.
Zielgenaue Mutation für hochreine Produkte
Das Bodenbakterium Corynebacterium glutamicum ist kein Unbekannter, es dient bereits als Produktionswirt für Aminosäuren wie Glutamat für die Lebensmittelindustrie. Die Ulmer Forscher verpassten dem Bakterium noch zwei funktionalisierte Gene und schon produzierte es reinstes Pediocin PA-1, ein antimikrobielles Peptid, das sich als besonders wirksam gegen Listeria monocytogenes erwies. Dieser Erreger kommt zwar ubiquitär vor, doch kann – über kontaminierte Lebensmittel wie Vollmilch oder Rohmilchkäse aufgenommen – zu lebensgefährlichen Listeriosen führen.
Die Devise: Kenne deine Synthese-Materialien
Der Kniff an der Produktion liegt in den Eigenschaften des Produzenten. „Corynebacterium glutamicum hat keine Rezeptoren, an denen das Bacteriocin andocken kann. Es ist daher resistent gegen dessen antibakterielle Wirkung. Ein Glücksfall für uns!“, betont Dr. Oliver Goldbeck, Wissenschaftlicher Mitarbeiter am Institut für Mikrobiologie und Biotechnologie und Erstautor der Studie. Auf diese Basis konnte das Forscherteam rasch aufbauen und ihre Arbeit auf großtechnischen Pilotmaßstab für die Industrieproduktion skalieren – bei vielen Forschungsabreiten scheitert es schließlich an derlei Schritten. Das gilt auch für die nächste Hürde: ein ressourcenschonendes, wirtschaftliches Verfahren zur Produktion zu entwickeln. „Anstatt teurer Nährmedien verwenden wir Abfallstoffe aus der Holzindustrie als Substrate für die Produktion“, erklärt Riedel, wofür es noch einer kleinen genetischen Veränderung am Bakterienstamm bedurfte. Doch es lohnte sich: „Dies macht es für unsere Bakterien möglich, Zucker und organische Säuren aus den Holzabfällen zu verwerten, um daraus schließlich die antimikrobiellen Peptide zu bilden“, sagt der Forscher. Also nicht nur ein neuer Ansatz, sondern auch noch umweltschonend und effizient umgesetzt – das Projekt wird daher durch einen internationalen Forschungsverbund gefördert.
Quelle: Informationsdienst Wissenschaft